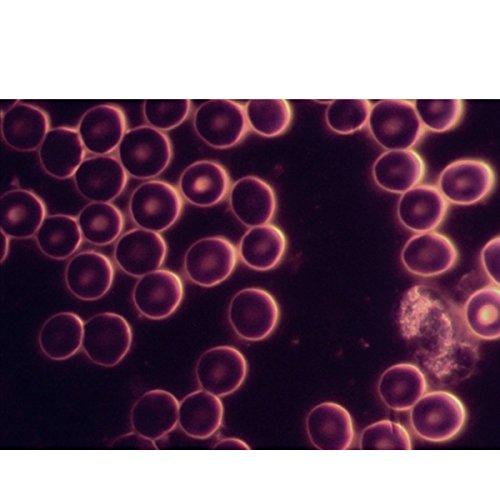
OMAX OMAX 40X-1000X Oil Darkfield Compound Binocular Microscope with 5.0MP USB Digital Camera

Description
- Total magnification: 40X-100X-400X-1000X; Eyepieces: widefield WF10X/18; Objectives: achromatic DIN 4X, 10X, 40X (S), 100X (S, Oil); Viewing head: 45 degrees inclined 360 degrees swiveling binocular; Interpupillary distance: sliding adjustable 2-3/16inch ~ 2-15/16inch (55~75mm); Diopter: adjustable on both eyepiece tubes
- Total magnification: 40X-100X-400X-1000X; Eyepieces: widefield WF10X/18; Objectives: achromatic DIN 4X, 10X, 40X (S), 100X (S, Oil); Viewing head: 45 degrees inclined 360 degrees swiveling binocular; Interpupillary distance: sliding adjustable 2-3/16inch ~ 2-15/16inch (55~75mm); Diopter: adjustable on both eyepiece tubes
- Total magnification: 40X-100X-400X-1000X; Eyepieces: widefield WF10X/18; Objectives: achromatic DIN 4X, 10X, 40X (S), 100X (S, Oil); Viewing head: 45 degrees inclined 360 degrees swiveling binocular; Interpupillary distance: sliding adjustable 2-3/16inch ~ 2-15/16inch (55~75mm); Diopter: adjustable on both eyepiece tubes
- Nosepiece: revolving quadruple; Stage: mechanical stain-resistant double layer size 5-1/2inch x 5-1/2inch (140mm x 140mm), translation range: 3inch x 2inch (75mm x 50mm); Focus: coaxial coarse and fine focus knobs on both sides, rack and pinion adjustment, with tension control; Focusing knob can be locked for observation and transportation; Brightfield condenser: NA1.25 Abbe condenser with iris diaphragm and filter holder, rack and pinion adjustment
- Oil darkfield condenser: NA 1.36-1.25 plus plan 100X/1.25-0.5 160/0.17 objective (oil, spring) with built-in iris diaphragm; Black palm rest on the base; Illumination: transmitted (lower), 6V 20W halogen light, variable intensity; Metal framework; Power supply: 100V~240V 50/60Hz worldwide range (US and Canada power plug)
- Digital camera: - true color 2592x1944 pixels (5.0MP) - 0.45X reduction lens to get larger field of view - Software compatible with Windows XP/Vista/7/8/10, and Mac OS - Capturing microscope images, recording live video, measuring lengths, angles, areas, editing images - USB cable included
- 5-year warranty against manufacturing defects
The professional binocular compound microscope provides darkfield & brightfield microscope system and an USB digital imaging system. The darkfield digital compound microscope comes with a sliding binocular head, large double layer mechanical stage, a halogen illumination system, 5.0MP USB digital camera, and brightfield Abbe NA1.25 condenser & oil darkfield NA1.36-1.25 condenser plus 100X objective with iris diaphragm. It offers four level magnifications from 40X to 1000X. The 2592 x 1944 pixels USB digital imaging system captures still microscope images and live video on computer. The included software compatible with Windows XP/Vista/7/8/10 can also be used to make measurements. You can also view and capture the images on iMac or Macbook with Mac OS. All lenses are made of high quality optical glass. The high resolution image in the field of view is crystal clear and will satisfy the demands of professionals. This binocular microscopy is good for teaching, demonstration, clinical examination and research purpose.